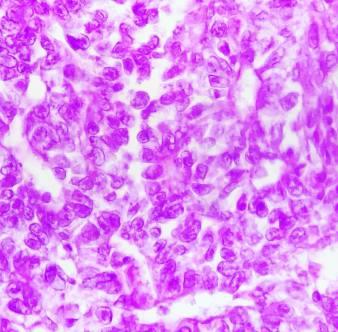

Hospital MediMAC Merida Plaza Avenida Correa Rachó UP TOWN, esquina calle 34 Diagonal, Mérida Yucatán. Teléfono: 999 478 7101 y 999 478 7100 Dentro de JUNIO 2023 AÑO 5 No. 61 REVISTA ESPECIALIZADA EN SERVICIOS MÉDICOS DE LA CIUDAD DE MÉRIDA, YUCATÁN D ctores Los EDICIÓN ESPECIAL Revista medimac.mx
Dermatología Pediátrica




// UDG Céd. Espec. 11622541
Acné - Vitiligo - Psoriasis - Hemangiomas

Dermatitis atópica - Verrugas virales - Revisión de lunares Dermatitis del área del pañal - Cicatrices
Dr. Vladimir Vázquez Ambriz Cirugía Plástica

Certificado C.M.C.P. 707

999 160 0090


MediMac Consultorio 10
Plaza Uptown Mérida, Av. Correa Rachó #34 Fracc. Vista Alegre
Vladimir Vazquez Cirujano Plastico
Dr.JuanCarlos PalominosEstrada
Especialistaen
Atención Integral del adulto y adulto mayor

Manejo de hipertensión arterial
Diabetes Mellitus
Enfermedades renales
Enfermedades respiratorias
Valoraciones preoperatorias

Enfermedades de dificil diagnóstico

CONTACTANOS:
TEL.9999251225




URGENCIAS:9991143263
• Rinoplastia
• Aumento de busto
• Lipoescultura de alta definición
• Cámara hiperbárica
• Implantes mamarios

• Lipectomia Adbominal
• Cirugía post Bariatrica
• Plasma Rico en Plaquetas
• Otoplastia


• Ritidectomía (face Lift)
• Botox
• Rellenos faciales
• Blefaroplastia


• Implantes de cabello
• Cirugía de invasión mínima
• Reconstrucción mamaria
• Reconstrucción cráneo-facial
CONSULTORIO


Dermatológico Terranova
Calle 33a entre 52 y 54 #465
Col. Centro, Mérida, Yucatán 9991 48 3190
MEDIMAC Mérida Plaza UpTown, Consult. 25



Av. Correa Rachó #104 por calle 34 Col. San Carlos, Mérida, Yucatán 993 57 1563
Certificado por el Consejo Mexicano de Medicina Interna 04975-18

Horario Pensiones: Martes, Jueves, Sábados 8:00 a 14:00 hrs. y 16:00 a 20:00 hrs.


Horario Medimac: Lunes, Miércoles 9:00 a 14:00 hrs.
Consult. 307

Calle 7 #215 x 32 y 34
Pensiones, Mérida, Mexico.
Especialista en:
Parto Humanizado
Parto en agua
Cesárea indicada
Embarazo de alto riesgo
Métodos anticonceptivos
Menopausia y climaterio

Colposcopia y papanicolaou
Enfermedades de trasmisión sexual Check up ginecológico


2 info@ doctores .mx los .com
Dr. Eliel Antonio Orozco Pichardo UADY Céd. Prof. 8942033
MedicinaInterna
Céd. Prof. UABJO 4316794 Céd. Espec. UADY 6156862
Col
Consult. 4 Av. Correa Rachó 104 Col. VistaAlegre, Mérida, Yucatán, (Plaza Uptown).
Dr. Juan Carlos Palominos Estrada drpalominosmedico
9992 26 97 99 Cel. 9999 47 57 06 Plaza Up Town / Medimac Consultorio 1 Callle 17 No.014A Col. Vista Alegre, Mérida. dratanger@guardianadelparto.com Obstetricia y Ginecología TÁNGER ARROYO LORANCA DRA. Ced. Prof. 4784912 Ced. Espec. 7730164 Dra. Tánger Andrea Arroyo www.guardianadelparto.com dra.tangerandrea
Hospital MediMAC
Merida
Dentro de la plaza UpTown Mérida
En los médicos que MediMAC Mérida colaboran con nosotros son prioridad, nuestras áreas están equipadas para que ejerzas tú práctica médica con seguridad calidad y calidez, brindándote las amenidades y atención que mereces, así como un equipo de colaboradores enfocados en brindarte un trato completamente personalizado.






Plaza Avenida Correa Racho, UP TOWN, esquina calle 34 Diagonal, Mérida Yucatán.
Teléfono: 999 478 7101 y 999 478 7100
CONTAMOS CON LOS SIGUIENTES ESPECIALISTAS EN NUESTROS CONSULTORIOS:
Oftalmología
Neumología
Ginecología
Pediatría
Urología

Nutrición
Oncología
Neurología
Nutriología
Cardiología
Endoscopia
Alergología
Dermatología

Reumatología
Traumatología
Anestesiología
Cirugía general
Cirugía plástica
Medicina Interna
Cirugía Bariátrica
Medicina Paliativa
Gastroenterología







Cirugía Oncológica





Otorrinolarigología
Cirugía Maxilofacial
Medicina del enfermo en estado crítico

NUESTRAS ÁREAS
UCI (Unidad de Cuidados Intensivos)
Consultorio general
Hospitalización
Área de Triage
Merida
MediMAC cuenta con el respaldo de Hospitales MAC con más de 13 años de experiencia en la administración hospitalaria y expansión comercial, procesos que han llevado al grupo de Hospitales MAC a ser la cadena hospitalaria más joven en México con el mayor crecimiento en todo el país.



Resonancia Magnética
Salade espera
Imagenología
Laboratorio
Quirófanos
Urgencias
Farmacia
Ambulancias Merida
info@ doctores .mx los .com 3
medimac.mx


































4 icia y ología TÁNGER ARROYO ORANCA DRA. . 4784912 Ced. Espec. 7730164 Revista Los Doctores Info. 9995 46 94 52 Implantes dentales Trauma facial Corrección de Maxilares (cirugía ortognática) Cirugía terceros molares Patologías de maxilares Cirugía Oral y Maxilofacial Implantes Dentales Ced. Espec. 7130382 UNAM Horario: Lunes a Viernes: 9:00 am a 1:00 pm y 4:00 pm a 8:00 pm Sábados: 9:00 am a 1:00 pm Hospital Star Médica 7o. piso Consultorio 720 Tel. (999) 9 43 60 10 Cel.: 9991 27 00 31 E-mail: dr.rodrigoflores@yahoo.com Dr. Rodrigo Flores Maxilofacial en Mérida www.maxilofacialenmerida.com www.implantesdentalesmerida.com.mx Dr. Fernando Cardeña Angulo PEDIATRA UADY Ced. Prof. 550701 AESSA 26662 feca12@hotmail.com Calle 26 No.199 x 15 y 7 Fracc. Altabrisa Consultorio 620 Tel. 99 99 43 30 03 Cel. 9999.47.18.29 ORIENTACIÓN RENATAL ediátricaP ORIENTACIÓN RENATAL eP diátrica En caso de fiebre ¿Qué le doy? ¿Qué uso para los cólicos? ¿Qué vacunas debe recibir? ¿Le debo vendar el ombligo? ¿Cuándo llega el destete? ¿Que leche debe tomar? ¿Defecación del bebé? Dr. Fernando Cardeña Angulo - Pediatra feca12@hotmail.com Dr.LorenzoH. ValladaresBasulto GinecologíayObstetricia Atención prenatalControl de embarazoPartoyCesareaEmergencia obstétricaPlanificación familiarConsulta de InfertilidadColposcopia y papanicolaouCheckup GinecológicoMenopausiaConsultorio 425 Calle 26 #199 x 15 y 7 Fracc. Altabrisa Tel. 9999 43 62 55 Cel. 9999 70 07 64 Lun. a Vier 10 a 13 hrs. y 17 a 21 hrs. drvalladaresbasulto@me.com Ced.Prof.5461384UNAM CMN20deNoviembre Antonio
Enfermedadesde: Próstata,Riñones,Vejiga Genitales,Infeccionesurinarias Litiasisurinaria Disfuncióneréctil Infertilidad HospitalStarMédica Calle26#199x7y15 Fracc.Altabrisa,Consult.404 Tel.9999437070 Calle 24 No. 280 Consult. 712 Temozón Norte, Santa Gertrudis Copó Tel. 9999 21 49 63 Cel.9992783333 antonioesqueda@hotmail.com www.urologoenmerida.com Cirugías: Cirugíaláserde próstataypiedra Laparoscopíaurológica Riñones,Cáncerurogenital Cirugíapercutaneadecálculos Endourología Láserparaincontinencia urinariasincirugía Termoablacióndetumores Vasectomiayrecanalizaciónde deferentes,varicocele.
Esqueda


















info@ doctores .mx los .com 5 Dra. Grethel Villanue Caballer Anatomopatóloga Céd. Prof. 7249000 Céd. Espec. 10047642 COMMAP 1622 Servicios de Laboratorio en Anatomía Patológica - Estudio histopatológico (biopsias y piezas quirúrgicas resección) - Estudio citopatológico (líquidos corporales) - Análisis de litos - Protocolos de investigación - Estudios especiales (moleculares) litos especiales info@cepae.mx www.cepae.mx Av. Alemán calle 4 No.123 Int. 1, por 17 y 19 Col. Felipe Carrillo Puerto, Mérida Yucatán. CEPAE cepae.mx 9993 33 8900 9993 53 0693
ADENOMA DE HIPÓFISIS


La hipófisis o glándula pituitaria es una glándula del tamaño de un guisante que se encuentra en la parte basal del cerebro justo por debajo del quiasma óptico, el cual es la unión de ambos nervios ópticos, y descansa sobre una estructura ósea en la base del cráneo llamada silla turca. Esta glándula se encarga controlar la producción de todas las hormonas del organismo y de esta forma regula el metabolismo basal, por lo que es conocida como “glándula maestra”.
El adenoma de hipófisis es un tumor originado a partir de las células que conforman la hipófisis. Este tumor se puede clasificar de acuerdo a su capacidad para secretar hormonas (funcionante o no funcionante) y (microadenoma o macroadenoma). Estas características son las que determinan la variedad de cuadros clínicos con los que se puede presentar. Dentro de los adenomas funcionales se encuentran los productores de hormona del crecimiento (GH), los cuales pueden generar cuadros de gigantismo en personas en desarrollo y acromegalia en adultos. De igual manera, se encuentran los productores de prolactina, quienes se manifiestan con esterilidad, alteraciones menstruales y galactorrea. También, se encuentran los liberadores de corticotropina (ACTH), que se manifiestan típicamente como la Enfermedad de Cushing la cual consiste en hipertensión, obesidad central, resistencia a la insulina (Diabetes Mellitus), cataratas, osteoporosis, estrías y cara en semiluna. En un número menor de casos se presentan los liberadores de tirotropina (TSH), que se manifiestan con un cuadro de hipertiroidismo caracterizado por irritabilidad, sudoración, exoftalmos, bocio, taquicardia y pérdida de peso involuntaria. En cuanto a su tamaño, los macroadenomas son considerados tumores con un tamaño igual o mayor a 1 cm, los cuales pueden generar síntomas como dolor de cabeza, alteraciones visuales caracterizadas por pérdida visual en la parte lateral de ambos ojos o ceguera

El tratamiento está enfocado de acuerdo al tamaño del tumor y si son productores o no de hormonas. El único tumor candidato a tratamiento médico es el productor de prolactina, mientras que el resto de tumores productores requieren tratamiento quirúrgico.
Los microadenomas no productores pueden vigilarse, mientras que los macroadenomas de acuerdo a las dimensiones del tumor y la accesibilidad para resecarlo se puede abordar por vía transnasal o transcraneal.
Para poder dar a conocer el alcance del tratamiento quirúrgico compartimos el caso de un paciente femenino de 41 años de edad quien acude a consulta por presentar obesidad central, diabetes mellitus e hipertensión de 1 año de


evolución. Sus laboratorios reportaron elevación de la ACTH, cortisol sérico y cortisol en orina de 24 horas, por lo que se solicitó una resonancia magnética cerebral encontrando un tumor en la hipófisis de 9.07 x 6.84 mm. De modo que, se decidió realizar resección del tumor por vía transnasal logrando extirpar la totalidad del tumor obteniendo como resultado la resolución de la enfermedad con normalización en los niveles de glucosa, adecuado control de la presión arterial y normalidad en los niveles de ACTH, cortisol sérico y cortisol en orina de 24 horas, los cuales se pueden ver esquematizados en la tabla 1 donde se comparan valores preoperatorios, postoperatorios y valores normales. La paciente actualmente ya no toma medicamentos para el control de su azúcar ni antihipertensivos, por lo anterior, se considera que la Enfermedad de Cushing ha desaparecido así como el tratamiento quirúrgico exitoso. dr rogerperez@yahoocommx

6 Revista Los Doctores Info. 9995 46 94 52
RM
Hormona Valores prequirúrgicos Valores postquirúrgicos Valores normales Hormona corticotropina (ACTH) 95.44 pg/mL 4.19 pg/mL 7.20 - 63.30 pg/mL Cortisol sérico 36.92 ug/dL 3.10 ug/dL 6.2 - 19.4 ug/dL Cortisol en orina de 24 horas 655 mg/24 hrs 141.8 mg/24 hrs 4.3 - 176 mg/24 hrs
Estado clínico prequirúrgico Estado clínico postquirúrgico
prequirúrgica (tumor hipofisiario) RM postquirúrgica (hipófisis normal)
por: Dr. Roger Pérez Castillo / NEUROCIRUJANO
● Hernia de disco
Dr. Roger Pérez Castillo NEUROCIRUGÍA



Especialista en cirugía de columna vertebral

Ced Prof 3222781 Ced Esp 5088034




● Tumores cerebrales, de médula espinal y columna vertebral.
● Cervicalgia, lumbalgia, ciatalgia

● Mielopatías
● Radiculopatía
● Adenoma de hipófisis
● Aneurisma cerebral

● Traumatismo craneoencefálico
● Fracturas craneales
● Hemorragias cerebrales
● Hidrocefalia
● Neuralgia del trigémino

Consultorio 27 Consultorio 612
Consultorio 318
dr_rogerperez@yahoo.com.mx www.neurocirujanoenmerida.weebly.com

Citas al 999 270 6513

info@ doctores .mx los .com 7
Servicio las 24 hrs. los 365 días del año
• Servicios de emergencia



• Transporte terrestre local y foráneo
• Médico a domicilio
Equipo de primera
24/7
Eventos deportivos, sociales, escolares, etc.

• Altas hospitalarias a domicilio
• Traslado programados
• Eventos especiales y deportivos
• Traslados de terapia intensiva
• Traslados con incubadora
• Convenios con empresas


• Personal capacitado y acreditado
• Licenciados en enfermería
• Permiso COFEPRIS en apegado a la NOM-034-SSA-2013 cisp@cisp.ca

9991 02 14 31

SERVICIOS DE ATENCIÓN PREHOSPITALARIA




8 Revista Los Doctores Info. 9995 46 94 52
AMBULANCIAS









info@ doctores .mx los .com 9 • MICROCIRUGÍA DE LA HIPÓFISIS Y REGIÓN SELAR
MICROCIRUGÍA DE HERNIA DE DISCO • CIRUGÍA DE TUMORES CEREBRALES
CIRUGÍA DE HERNIA DISCAL CERVICAL
CIRUGÍA DE LESIONES CEREBRALES • BIOPSIA DE NERVIOS PERIFÉRICOS • BIOPSIA CEREBRAL • TUMOR CEREBRAL EN NIÑOS • TUMOR CEREBRAL EN ADULTOS • HIDROCEFALIA • ENFERMEDAD CEREBROVASCULAR • HEMORRAGIA CEREBRAL • DERRAME CEREBRAL • DISCO ROTO • CIÁTICA • ANEURISMA CEREBRAL • ADENOMA SECRETANTE Dentro de la plaza UpTown Consultorio 711 Cédula Profesional: 2659973 Cédula Especialidad: 4896511 Urgencias: 9999 47 2495 Hospital Faro: 9999 21 4962 Star Médica: 9999 43 3334 Consultorio 417
LUISALBERTO RAMÍREZ LÓPEZ Cirugía Neurológica, Cirugía Cerebrovascular, Cirugía de Columna Vertebral. www.neurocirujanodrramirez.com
•
•
•
DR.
Riesgos y consecuencias de LA HIPERTENSIÓN ARTERIAL
La hipertensión arterial es generalmente una afección crónica que causa daño progresivo en el transcurso de los años. Sin embargo, a veces la presión arterial aumenta de manera tan rápida y grave que se convierte en una emergencia médica que requiere tratamiento inmediato, a menudo con hospitalización.
El corazón ejerce presión sobre las arterias para que éstas conduzcan la sangre hacia los diferentes órganosdelcuerpohumano.Estaacciónesloquese conoce como presión arterial. La presión máxima se obtiene en cada contracción del corazón y la mínima concadarelajación.
Lapresiónarterialalta(hipertensión)puededañarde manera discreta el organismo durante años antes de quesemanifiestenlossíntomas.
El diagnóstico se basa en un sencillo procedimiento de medición, aunque en algunos casos son necesarias otras pruebas como el holter de presión arterial. Es imprescindible completar el estudio con un análisis de laboratorio (de sangre y orina) y un electrocardiograma.
Tener la presión por encima de los valores ideales conlleva un mayor riesgo de infarto de miocardio, insuficiencia cardíaca, accidente cerebrovascular, demencia y enfermedad renal crónica. Además de aumentar el riesgo de muerte prematura, los que sobreviven a un evento de estas características, sufren disminución de la calidad de vida y mayor riesgodeinvalidezalargoplazo.

Es importante conocer los síntomas de las enfermedadesqueserelacionanconlahipertensión, como puede ser dolor torácico, dificultad en la respiración o sensación de ahogo, edemas, es decir, hinchazón causada por la acumulación de líquido en los tejidos del cuerpo, sangre en la orina, dolor en piernasalrealizaralgúntipodeactividadfísica,entre otros.
Teniendo en cuenta lo dicho anteriormente, de manera indirecta se puede descubrir que el paciente eshipertenso.
Cuando hablamos de un tratamiento para la hipertensión ésta debe ser individualizado de acuerdo con las características de cada paciente, pero en líneas generales podemos decir que el mismotienetrespilaresbásicos:Ladieta,elejercicio físicoregularylosfármacosantihipertensivos. Cambiar los hábitos alimenticios y ejercitarse, además de contribuir a lograr el objetivo de bajar los valores de la presión, mejora el perfil metabólico, ayuda a mantener un peso saludable, desciende los nivelesdecolesterolyprevieneladiabetes.
Medicina interna. Céd Prof. 5088355


Consult. 909

Calle 24 280, Temozón Norte, Santa Gertrudis Copo.
TEL: (999 ) 904 1457




10 Revista Los Doctores Info. 9995 46 94 52
DR. LUIS MIGUEL ESTRADA FIGUEROA
DR. LUIS MIGUEL ESTRADA MEDICINAINTERNALM
Hospital Faro del Mayab
Litiasis renal.

¿Qué es?
La litiasis renal es un problema de salud la vía urinaria, en donde diferentes biomateriales en la orina se sobresaturan y cristalizan, desequilibrando las sustancias favorecedoras y protectoras c o n t r a l a f o r m a c i ó n d e l i t o s, comunmente conocidos como piedras, encontrándose éstos en diferentes sitios de la vía urinaria.


¿Cuáles son las causas?
La causas se asocian a diferentes factores como son: ambientales, regionales y geográficos, raciales, ocupacionales, hábitos dietéticos, estilo de vida, polimorfismos genéticos, alteraciones metabólicas, la herencia familiar, bajo consumo de agua y calidad de la misma.
La litiasis renal en la Península de Yucatán.
La incidencia de la litiasis renal en la Península de Yucatán es muy alta, siendo uno de los

padecimientos atendidos con mayor frecuencia en la consulta de urología; por ello la importancia de acudir a su urólogo de forma frecuente a revisión para evitar complicaciones secundarias a los litos
¿Cómo se diagnóstica?
Se realiza el diagnóstico mediante una historia clínica detallada del paciente, donde nos refieren cólicos nefríticos y por sospecha clínica se realiza ultrasonido renal o tomog rafía computarizada (TC).


¿Cómo se trata?
El tratamiento va de acuerdo al sitio en donde se encuentra el lito. Existen diferentes tratamientos que van desde tratamiento médico para expulsión de los litos sin necesidad de operación, hasta cirugías de mínima invasión como lo es la nefrolitotomía percutánea , ureteroscopía flexible y semirígiada con destrucción de los litos con energía láser.
¿Qué son las cirugías de mínima invasión?
En la actualidad existen diferentes y novedosas técnicas quirúrgicas para tratar la litiasis renal, cuya característica principal es que ya no se realizan heridas de gran tamaño (en la actualidad menores a un centímetro) o incluso si las circunstancias lo permiten estas se realizan sin la necesidad de una herida, esto dependerá del tamaño y sitio donde se localice la piedra.
info@ doctores .mx los .com 11
Fernando
Cirujano uró logo certificado Cédula de especialidad: 419737 StarMédica, consultorio 716 Tel. 999 903 9658 Citas: 999 256 3615 Urólogo Fernando Pérez Garfias urologo_fernando_pg
Dr.
Pérez Garfias
Crónicas de un Ortopedista apasionado, ejerciendo su vocación
Soy el Dr. Leonardo Sebastián Ortiz Aguilar, Traumatólogo ortopedista, y quiero llevarte a través de este breve artículo, a que me conozcas como persona, y como profesionista de la salud.

Inicialmente, quiero compartirte 5 escenarios de padecimientos que frecuentemente resuelvo en la consulta de Y posteriormente Ortopedia aconsejarte 3 tips para que logres una consulta satisfactoria cuando vayas con tu Ortopedista.
1 ¿Doctor, tengo que operarme para que se me quite el dolor de rodillas? No. Tenemos diferentes tratamientos que debemos intentar antes de llegar a un tratamiento quirúrgico.
Debemos estudiar tu caso con una muy buena exploración física, saber a qué te dedicas y qué actividades realizas a diario para poder planificar el tratamiento
2. Doctor, vengo por un dolor en mi brazo, que al inicio era leve, pero después fue intensificándose y limitando su movimiento. Actualmente ya no puedo bañarme, ni vestirme y el dolor empeora por las noches al acostarme sobre mi hombro, ¿qué está provocando este dolor?
Frecuentemente se debe a una lesión subacromial, que compromete el mango rotador, el cual, es una serie de 4 tendones que nos permiten movimientos indispensables para alimentarnos, asearnos, peinarnos y vestirnos.
El hombro es la articulación más móvil del cuerpo humano Si logramos hacer el diagnóstico temprano, podemos evitar el dolor y mejorar la movilidad del hombro.
3 ¡Me duele mi cintura Doctor! El dolor me llega hasta los pies, no me deja moverme y mis pies están entumidos
Medicamente llamamos “lumbalgia”, al dolor que abarca la parte baja de la espalda La incapacidad para poder agacharnos y enderezar nuestra columna vertebral puede ser ocasionada por una contractura muscular dolorosa. Cuando el dolor se acompaña de alteraciones de la sensibilidad puede ser ocasionado por una hernia de disco que comprime el nervio ciático. Si este fuera el caso, deberemos realizar una resonancia magnética para evaluar la magnitud de la hernia y poder tratarla.

4 Doctor, ya recibí múltiples sesiones con el quiropráctico y mi dolor persiste.
Actualmente en Ortopedia es importante un tratamiento multidisciplinario conformado por Fisioterapia y rehabilitación. Esto con el fin de evitar una pérdida de fuerza muscular, que limita la función de las articulaciones
5. Tengo un dolor en la muñeca que se intensifica al momento de sujetar objetos con la mano, también he notado que el dolor se irradia hacia el antebrazo
Las tenosinovitis del pulgar son cada vez más frecuentes, esto se debe al uso excesivo del celular Es importante identificarlo tempranamente para evitar una cirugía
Tips para un resultado satisfactorio en la consulta de Ortopedia y Traumatología:
1 , te recomiendo no dejar pasar más de 3 Acudir al inicio del dolor semanas. Habitualmente cualquier dolor que se mantenga por más de 3 semanas puede dejar secuelas que limiten tu movilidad y hacer más difícil la rehabilitación.
2 , me refiero a si ¿hay algún Ponle atención a lo que involucra tu dolor predominio de horario?, ¿cuándo se presenta tu dolor?, ¿alguna postura lo calma o lo hace más intenso?, ¿se acompaña de alguna alteración de la sensibilidad? Y tratar de identificar el sitio anatómico preciso del dolor y sus irradiaciones
3. Hazle saber a tu ortopedista todas tus enfermedades, alergias y medicamentos que tomas o te aplicas, nos aporta información fundamental en tu historia clínica y nos es relevante para brindarte un tratamiento individual y óptimo
Salud, es un estado de completo bienestar físico, mental y social. Acude oportunamente a tu revisión médica, para que juntos podamos ocuparnos del bienestar físico, mental y social Porque la vida es movimiento constante, y será un placer poder ayudarte a recuperar tu vida sin dolor.
Estoy para ayudarte en el del hospital , dentro de la consultorio 26 MediMac plaza UpTown Mérida
Dr.
Sebastián Ortiz Aguilar
Alta especialidad en artroscopía de rodilla, hombro y ortopedia del deporte

Consultorio 26, Medimac Plaza UpTown Mérida, Av. Correa Rachó #104A, Col. Vista Alegre, Mérida, Yuc


Celular: 99.0101.0916


drleo.ortovida
www.ortopedistaenmerida.mx


12 Revista Los Doctores Info. 9995 46 94 52
Leonardo
Dolor de rodilla, hombro, cadera, muñeca, lumbalgia y nervio ciático.
Ortopedia del Deporte de Alto Rendimiento Traumatología
Recientemente en la consulta de dermatología atendí a una mujer de 33 años que me comentó que tenía muchos brotes de acné, sensación de resequedad y comezón en la cara. Al interrogarla sobre su rutina de cuidado de la piel, me llamó la atención que usaba la misma crema del cuerpo para hidratar su cara, además solía desmaquillarse cada noche con aceite de oliva. Sospeché de inmediato en una enfermedad por ácaros y decidí tomar un estudio de su piel para observarlos al microscopio y así, confirmar una demodecidosis.




A propósito de la consulta, los invito a habar un poco de la demodecidosis; se trata de una enfermedad provocada por un ácaro del género Demodex. Dicho ácaro, suele ser un comensal de las unidades pilosebaceas, es decir, es normal que todos tengamos estos parásitos en la cara. Sin embargo, en pieles muy grasosas o que se aplican muchas sustancias oleosas, los ácaros sobrepoblan e irritan la piel, provocando sensación de comezón intermitente, a veces granitos rojos y resequedades.


La demodecidosis, predomina en el sexo femenino y suele afectar más a los adultos que a
los niños. Para diagnosticar esta enfermedad, se puede realizar una biopsia superficial muy sencilla en el consultorio y hacer una cuenta de dichos parásitos; más de 5 ácaros por cm2 se considera diagnóstico de demodecidosis.
El tratamiento se realiza con antiparasitarios tópicos o vía oral y lavados con sustancias como el disulfuro de selenio. Como prevención debemos evitar utilizar aceites de comida para desmaquillar o cremas muy grasosas en cara y preferir siempre productos dermatológicos.
Si tu o alguno de tus familiares tiene granitos, comezón o resequedad en la cara no duden en acercarse a la consulta para hacer un diagnóstico oportuno e iniciar un tratamiento adecuado.
Dra. Brenda Hermosillo DERMATÓLOGA
•Especialista certificada en piel, pelo y uñas. Céd. Prof. 10104226 Céd. Espec. 12974727




info@ doctores .mx los .com 13
dermatológica, hablemos
DEMODECIDOSIS Consultorio 26, Medimac Plaza UpTown Mérida, Av. Correa Rachó 34, Col.
A propósito de la consulta
de:
Vista Alegre, Mérida, Yuc. 221 271 4880
Acné, Melasma o paño, Rosácea, Verrugas, Uñas enterradas, Alopecias o caída de cabello, Hongos en el cuerpo o en las uñas, Vitiligo, Psoriasis, Dermatitis atópica, Dermatitis seborreica o caspa, Enfermedades autoimmunes como lupus, Enfermedades ampollosas como pénfigo y Cáncer de piel como Melanoma.
Dra. Brenda Hermosillo drabrenda.hermosillo@gmail.com
bh.derma
DR. ISRAEL GONZÁLEZ GONZÁLEZ


MAYAB Céd. Prof. 6738453 UNAM Céd. Espec. 10003946
israelgzzgzz@gmail.com



Cirugía Bariatrica y Metabólica:

- Manga Gástrica - Bypass Gástrico

- MiniBypass Gástrico - Balón Intragástrico

- BARICLIP - SADIS - Cirugía de Conversión/Revisión

Consultorios 14 y 15





Calle 17 No.104-A Interior N-1
Col. Vista Alegre C.P. 97130

Plaza Up Town, Mérida Yucatán.
Cirugía Gastrointestinal por Mínima Invasión:

- Cirugía Antirreflujo
- Cirugía de Vesícula Biliar
- Apendicectomía
- Cirugía de Hernias

- Cirugía Gastrointestinal Avanzada.
Diagnóstico y tratamiento de:
– Trastornos metabólicos
– Diabetes Mellitus

– Hipertensión arterial

– Colesterol alto
– Triglicéridos altos
– Ácido úrico alto

– Hígado graso
– Obesidad
– Enfermedades del corazón
– Enfermedades respiratorias


– Problemas digestivos
– Gastritis
– Intestino irritable

- Reemplazo articular (colocación de prótesis)
- Cirugía artroscópica
- Dolor articular (hombro, cadera y rodilla)



- Lesiones deportivas
H- Lesiones ligamentarias y tendinosas
- Desgaste del cartílago
- Dolor lumbar (columna)
- Osteoporosis - Pie plano

14 Revista Los Doctores Info. 9995 46 94 52 Calle 16B No. 315 x 17a y 19 Fracc. Paraíso Maya, Mérida, Yuc. 99 92 55 77 33 99 93 64 47 44
Cirugía Bariátrica
de Mínima Invasión Especialista
y
Certificado en Cirugía Bariátrica / Metabólica y Laparascopía Avanzada
Céd. Prof. 8711491 Céd. Espec. 11301470 Alta especialidad en Cirugía Articular Star Médica, Mérida Consultorio 821 9997 09 4478 / 9993 8927 60 Ortopedia y Traumatología Hospital MediMAC Consultorio 16
Escudero
Escudero BUSCANOS EN
Dr.
Daniel
Dr. Daniel
secuelas COVID-19 Especialista en Medicina Interna Consultorio 307, Av. Alfredo de la Barrera #215-A por 32 y 34, Col. Pensiones, Mérida Yucatán. Tels.: 9995 11 47 19 Urgencias: 9992 22 63 63 Céd. Prof. 3459229 Céd. Espec. 5201332 contacto@drjosehernandez.com.mx www.drjosehernandez.com.mx DrJoseHernandezMedico
– Tratamiento y
CENTRO MEDICO PENSIONES drjosehdezmedico Consultorio 4 Av. Correa Rachó esquina diagonal 34, Col. Residencial San Carlos, C.P. 97133 Mérida Yucatán. (interior Plaza Uptown) mediMAC
Dr. José Hernández Zenteno
La pancrea��s aguda (PA) es una inflamación del páncreas que puede evolucionar hacia la necrosis pancreá�ca por autodiges�ón. Es benigna en el 80% de los casos.

Los factores de riesgo para PA son sobrepeso y obesidad, consumo excesivo de alcohol y alimentos ricos en grasa, tener cálculos en la vesícula y vías biliares, niveles de triglicéridos elevados mayor o igual a 1000 mg/dL.
La pancrea��s aguda (PA) es frecuente y es la principal causa de visitas a urgencias por dolor abdominal agudo. Su incidencia varía entre 1545 casos por cada 100.000 personas al año en todo el mundo, y está aumentando debido al incremento de la obesidad. La mortalidad global oscila entre el 3-5%, pero puede alcanzar el 35% en las formas necrosantes complicadas.
La causa más frecuente (35-40%) de la PA es la li�asis biliar, incluidas las microli�asis y el barro biliar El alcohol representa la segunda causa más frecuente de PA (30%). En estos pacientes a menudo existe una pancrea��s crónica de base, que puede ser di�cil de diagnos�car por cursar con cambios mínimos. Un consumo de alcohol >50-60g/día de forma crónica, o un exceso puntual permiten catalogar el alcohol como factor causante. El consumo de tabaco es un factor de riesgo independiente de PA y un factor acelerador de la progresión de la pancrea��s crónica.
Síntomas
Se manifiesta por dolor intenso en abdomen superior "arriba del ombligo". El dolor puede correrse a la espalda y hombro izquierdo, se acompaña de náuseas, vómito persistente y en ocasiones fiebre. Distensión abdominal, dolor a la palpación abdominal y disminución de ruidos intes�nales. Puede presentarse coloración amarillenta de conjun�vas y piel, así como orina muy oscura en caso de que la pancrea��s sea provocada por cálculos biliares Síntomas de deshidratación severa, como son: confusión mental, piel seca y caliente, la�dos cardiacos aumentados, respiración rápida y superficial, presión arterial baja, poca producción de orina.
Diagnós�co
Los estudios de laboratorio y radiológicos son muy importantes para confirmar el diagnós�co de pancrea��s aguda y descartar otros problemas que se manifiestan con dolor abdominal agudo (úlcera pép�ca perforada, infarto cardiaco, obstrucción intes�nal, cólico renal, neumonía).

Se requieren análisis de sangre para detectar niveles elevados de enzimas pancreá�cas, glóbulos blancos, función renal y enzimas hepá�cas. Ecogra�a y/o tomogra�a computarizada para detectar cálculos biliares e inflamación del páncreas. En algunos casos se requiere de resonancia magné�ca, ecogra�a endoscópica.
Clasificación de pancrea��s aguda
PA leve: proceso inflamatorio pancreá�co agudo con mínima repercusión de síntomas sistémicos.
PA grave: se asocia a fallas orgánicas sistémicas o a complicaciones locales como necrosis, pseudoquiste o absceso, requiriendo vigilancia en una unidad de cuidados intensivos.
Tratamiento
El tratamiento temprano de la pancrea��s aguda es primordial para limitar complicaciones y disminuir el riesgo de muerte. Corregir deshidratación con administración de líquidos y electrolitos por vía intravenosa para evitar otras complicaciones como insuficiencia renal aguda, control del dolor y en caso necesario dar tratamiento quirúrgico/endoscópico si se trata de una pancrea��s aguda infectada.



Prevención
Al disminuir factores de riesgo, es posible evitar la pancrea��s aguda, por lo que recomiendo lo siguiente.
• Bajar de peso, en caso de obesidad y sobrepeso.
• Suspender el consumo de alcohol.
• Tener alimentación saludable rica en verduras, fibra, fruta y agua.
• Evitar el consumo de alimentos ricos en grasas, así como alimentos "chatarra" y bebidas azucaradas.
• Realizar ejercicio aeróbico de manera periódica por 30 minutos al día.
• Acudir al médico para diagnós�co y tratamiento temprano de:
o Cálculos en la vesícula para realizar colecistectomía temprana.
o Cálculos en las vías biliares para realizar CPRE (colangiopancreatogra�a retrógrada endoscópica).


o Trastorno en metabolismo de grasas o enfermedades relacionadas con colesterol o triglicéridos elevados en sangre y/o problemas hormonales iniciar tratamiento bajo vigilancia médica.

●Gastroenterología


●Endoscopia
●Cirugíageneral
●Prótesishíbrida
●Cierredecolostomía
●Cirugíadeherniahiatal
●Cirugíadeherniaventral
●Cirugíadeherniaumbilical
●Extraccióndecuerposextraños
●Apendicectomiaporlaparoscopia
●Colecistectomíaporlaparoscopia
●Laparascopiadiagnósticaconbiopsia
●Cirugíaantirreflujooherniahiatal
●Extirpacióndetumoresbenignoscutáneos
●Cirugíadelaherniayeventracióncon resecciónintestinal
●Colecistectomiaporlaparotomia
●Cirugíasimpledelaherniaylaeventración
●Panendoscopiaoraldiagnóstica

●Rectosigmoidoscopiaconbiopsia
●Polipectomiagástricaendoscópica
●Esclerosisendoscópica
●Segundaopiniónmédica
info@ doctores .mx los .com 15
PANCREATITIS AGUDA
CirugíaGeneral,Laparoscopíay EndoscopíaGastrointestinal
5559452319
MedimacConsultorio01 CentrocomercialUpTown, AvenidaCorreaRachó34,Mérida,Yuc e-mail:jimenatp19@gmail.com doctoralia.com.mx/z/kmw7g6
Dra.JimenaTorresPacheco
Dr. Cesar Alberto Contreras Herrer

Atención a pacientes en estado crítico, hipertensión, diabetes descontrolada y todo tipo de urgencias 24 horas.
Cardiología - Hemodinamia


- Manejo de hipertensión arterial

- Arritmias
- Angina de pecho
- Infarto miocárdico
- Enfermedades valvulares

- Colocación y revisión de marcapasos cardiaco
- Cateterismos de corazón
Estudios Cardiológicos:
* Electrocardiograma.
* Prueba de esfuerzo.
* Ecocardiografía.


* Holter de ritmo cardiaco.
* Monitoreo ambulatorio de presión arterial.

* Prueba de inclinación
● Cardiomiopatía isquémica

● Obesidad
● Insuficiencia cardíaca




● Cirrosis

● Hipertensión


● Presión arterial alta (Hipertensión)

● Gastritis crónica


● Cardiopatía hipertensiva
Urgencias . Pérez Ponce por Av. Montejo y calle 56 Col. Centro
Dr. Wilberth Raúl Méndez Vivas









16 Revista Los Doctores Info. 9995 46 94 52
Dr. Gilmer Cetina Domínguez CARDIÓLOGO
Consultorio 326 3er piso Calle 7 # 215-A x 32 y 34 García Ginerés Tel. 9999 20 00 70
Interior Plaza Uptown, Consultorio 28 Av. Correa Rachó #104, Col. Vista Alegre, Tel. 9995 76 63 93
Centro Médico Pensiones Céd. Prof. 4281288 UADY Céd. Espec. 6544909 Universidad Autónoma de Nuevo León A viso de publicidad 31A V0032020
URGENCIAS: Cel. 9992 50 7601
MEDICINA INTERNA
● Enfermedad renal ● Enfermedad articular degenerativa ● Enfermedades de la tiroides ● Diabetes tipo 2 ● Cirrosis o hepatitis alcohólica ● Enfermedad pulmonar ● Asma ● Enfermedades Infecciosas ● Infección urinaria cesar0380@hotmail.com Céd. Prof. 4513519 Céd. Espec. 6725277 Medimac Consult. 23, 1er Piso calle 17 #104A Col. Vista Alegre Plaza Uptown Tel. 9991 29 5174 Cel. 9992 78 1611 Centro de Especialidades Médicas Consultorio 19, 1er. Piso Calle 60 por Av. Colón y calle 35 Col. Centro, Mérida Yuc. • Medicina general • Niños • Adolescentes • Adultos • Embarazadas • Urgencias Universidad Anáhuac Mayab Céd. Prof. 10800517 Registro ante CONAMEGE: 20/01/31-159-20413 9993 94 85 03 9993 38 26 55 Dra. Stephanie J Pereira Lopez dra.stephaniepereira Clínica M&M Especialidades Médicas CIRUGÍA ONCOLÓGICA Y LAPAROSCOPÍA AVANZADA
Certificado por el Consejo Mexicano de Oncología UNAM 8567091 UADY 4530325 UADY 5941906 Máster en laparoscopia ginecológica, España. Consult. 3, Av. Correa Rachó 104 Col. Vista Alegre, (Plaza Uptown). dr.wilberthmendez@hotmail.com www.inlapsur.com Tel. (999) 429 99 11 Urgencias y dudas: Cel. 9999 47 90 68
Diagnóstico y tratamiento avanzado de todo tipo de cáncer
Cirugía conservadora en cáncer de mama. - Cirugía hepatopancreatobiliar
Cirugía en cáncer por mínima invasión. - Ablación de tumores Calle 25 No. 210 entre 26 y 28 Col. García Ginerés, Mérida, Yucatán. Tels. 999 925 03 87 / 999 941 77 65 www.centrodeendoscopia.com.mx Prevención, diagnóstico, tratamiento y paliación del cáncer. CENTRO MEXICANO DE ENFERMEDADES DIGESTIVAS Urgencias: Consult. 2, Av. Correa Rachó 104 Col. Vista Alegre, (Plaza Uptown).
-
-
-
Ojo Seco y Disfunción de las Glándulas de Meibomio
Primero definiremos qué son las glándulas de meibomio (GM), son glándulas que producen una secreción lipídica llamada meibum Este compuesto forma parte de la capa lipídica (capa grasa) de la lágrima, lo que promueve la estabilidad de la película lagrimal y protege de la evaporación.
La disfunción de Glándulas de Meibomio (DGM) se caracteriza por una secreción de lípidos alterada
¿Sabes cuántas personas tienen DGM?
Al menos 4 de cada 10 personas tendrán algún signo de DGM
Factores de riesgo para padecer DGM
Oftálmicos
Blefaritis anterior
Uso de lentes de contacto

Demodex
Tatuaje de párpados
Síndrome de párpado caído
Conjuntivitis alérgicas



Parpadeo deficiente
Síndrome de Ojo seco
Sistémicos
Envejecimiento
Menopausia
Párkinson
Ovario poliquístico
Psoriasis
Rosácea
Hipertensión
Sindrome de Sjogren
Relacionado con Medicamentos
Consumo de Isotretinoina
Antiandrógenos
Antidepresivos
Antihistamínicos Medicamentos para la próstata

Síntomas de DGM
Párpados hinchados al despertar
Antecedentes de orzuelos y chalazión (perrillas )
Sensación de arena en los ojos
Síntomas de ojo seco que tienden a empeorar en las mañanas
Signos
Lágrima espumosa
Párpados enrojecidos
Técnicas de diagnóstico para la DGM
Examen oftalmológico con lámpara de hendidura
Expresión de las GM para evaluar la alteración de la secreción de las glándulas de Meibomio
Meibografía que es un estudio especial para glándulas de meibomio
Estabilidad de la lágrima, morfología de los párpados, entre otras pruebas especiales en el consultorio.
Cómo se relaciona la DGM con el síndrome de ojo seco
El daño de la superficie ocular resultante del aumento en la evaporación de las lágrimas, la hiperosmolaridad, los mediadores proinflamatorios en las lágrimas, pueden dar lugar a síntomas de irritación de la superficie ocular y los párpados. Muchos de estos signos y síntomas oculares se sobreponen entre la DGM y el SOS,
que también comparten muchos factores de riesgo oculares comunes, sistémicos y relacionados con el tratamiento
Se identican dos tipos:
Resequedad ocular evaporativa o deficiente en lípidos causada por la evaporación del agua Es la forma más frecuente de SOS Se considera que la DGM es la causa más común del SOS evaporativo y se identifica como un punto de entrada potencial en el círculo vicioso del SOS.
Resequedad ocular con deficiencia acuosa causada por la disfunción de las glándulas lagrimales, que se clasifica en síndromes de Sjögren y de no Sjögren
Tratamiento:
El tratamiento de la DGM tiene como objetivo final aumentar la cantidad y la calidad de la expresión de Meibomio y, por tanto, mejorar los síntomas del paciente
Los planes de manejo deben incluir una rutina general de 3 pasos: Calentamiento de los párpados, Masaje y Limpieza.
Esta rutina puede ser suficiente para algunos pacientes pero puede complementarse con tratamientos físicos únicos y/o terapias medicinales orales y tópicas, según se requiera
Además existen nuevas tecnologías como IPL, Jett Plasma o procedimientos quirúrgicos que tu oftalmólogo evaluará según sea el caso.
Dra. Marimar Martínez Ramos Oftalmóloga certificada - Especialista de Ojo Seco en New View

Dra. Fabiola Ordóñez Aguilar Oftalmóloga Alta Especialidad en Retina y Vitreo C.E 10830331 CMO 3800
Dra. Marimar Martínez Ramos Oftalmóloga
Alta Especialidad en Cirugía de Catarata Máster en Medicina Estética C.E. 10509200 CMO 4121
Oftalmología
Especializada
Consultas adultos y niños
Cirugía con láser para glaucoma, Retinopatía Diabética, Miopía, Hipermetropía y astigmatismo

Spa
Máscara ocular para relajación
Tratamiento de ojo seco con Jett plasma
Tratamiento de Glándulas de Meibomio
Masajes con drenaje linfático ocular
Plaza uptown Medimac Consultorio 6
Toxina Botulinica Peelings Microneedling con dermapen
Jett plasma Medical
NewViewoys@gmail.com newview_mid
info@ doctores .mx los .com 17
Cirugía de cataratas Cirugía de Retina y vítreo Medico Ocular Medicina Estética
Tratamiento de ojeras Relleno de ácido hialuronico
9993665981
ORTOPEDIA,

PIE DIABÉTICO VARICES
INSUFICIENCIA VENOSA
ÚLCERAS VASCULARES
Citas: 9999 26 09 24
Cel: 9996 04 57 00

Edificio Platino CMA, Consultorio 6, Calle 56 Nº 494-C por Av. Perez Ponce, Col. Centro




Tepal
-Circuncisión



-Vasectomía
-Varicocele
-Eyaculaciónprecoz
-Disfuncióneréctil
-Incontinenciaurinaria
Vías

-Enfermedadesdelapróstata
-Piedrasenlosriñones
-Tumoresderiñón,vejiga, próstataytestículo
-Enfermedadesdelavejiga
-Virusdelpapilomahumano
Av. 7 No. 215-A
Urología Cirugía de mínima invasión (cirugía láser y laparoscópica)





Dra. Karla Sugey Reyes
Ginecología - Obstetricia Colposcopía - Sexualidad












• Embarazo
• Miomas uterinos
• Embarazo de alto riesgo•
• Menopausia
• Virus del papiloma humano (VP
• Amenaza de aborto
• Endometriosis
• Diabetes gestacional













• Sangrado uterino disfuncional
• Infertilidad
• Colposcopia
• Sexualidad
• Enfermedades de la mujer
18 Revista Los Doctores Info. 9995 46 94 52
Av. Correa Rachó 104 Col. Vista Alegre, Mérida, Yucatán, (Plaza Uptown).
Hospital Star Médica Calle 26 No.199 Fracc. Altabrisa Piso 6 Cons. 608
Ginecología - Obstetricia, Dra. Karla Sugey Reyes Díaz
TU SALUD ES PRIORIDAD
Céd. Prof. 7065031 999 196 0480
Dra. Marina Durán Angiología, cirugía vascular y endovascular. e-mail: dramarinaduran�gmail.com
Hospital MediMAC Av. Correa Rachó 104 Col. VistaAlegre, Mérida, Yucatán, (Plaza Uptown).
Céd. Prof. ������� Céd. Esp. ��������
Céd. Pro Céd. Espec
urinarias del hombre y la mujer
por 32 y 34 Col. García Ginerés, Mérida Yuc Torre Médica Pensiones (interior estacionamiento) Consultorio 111 9993 39 3020 Cel. 9991 42 5032 y 9995 52 0895 Previa cita: TORRE MÉDICA P E N S I O N E S
-Enfermedadesde trasmisiónsexual Dr.Sergio UROLOGÍA TepalDr.Sergio UROLOGÍA
TRAUMATOLOGÍA, CIRUGÍADECOLUMNA. YOUR ADDRESS HERE Tel. 9999 26 6348 Cel. 9992 42 1256 Calle 54 No. 363 por Av. Pérez Ponce Consultorio 9, primer piso, edificio anexo, Mérida. rickpechl@hotmail.com DGPEsp.152005-Céd.Prof.2604156UADY-Céd.Espec.4152005IMSS Dolordeespalda Cirugíamínimoinvasiva Fracturasvertebrales Dolordeciática Escoliosis (deformidadesdecolumna) Herniadedisco Crujidootronidodelcuello Urgencias 24 Horas - Atención a Domicilio - English Spoken Dr. Ricardo Pech Lorenzana Columna Yucatán CirujanodeColumna. Medicoespecialistaenenfermedades delaespaldaydelacolumnavertebral. Atenciónatodoslosgruposdeedades
Dr.RicardoPechLorenzana
La
La manga gástrica es un procedimiento restrictivo que limita la cantidad de alimento que puede comer el paciente, reduciendo el tamaño del estómago Normalmente, el estómago tiene una capacidad de 1 a 1.5 litros de comida. Durante una manga gástrica se crea un tubo delgado, reduciendo el estómago al 15% de su tamaño normal, utilizando un instrumento de grapeo. Esta manga, está calculada para tener una nueva capacidad de 120 a 150 ml.
Esta cirugía se realiza por laparoscopía (cirugía de mínima invasión) realizando muy pequeñas incisiones en el abdomen y bajo anestesia general. La finalidad de la cirugía: Extraer el 85% del estómago, parte del cual, lo forma el fondo gástrico que tiene mucha importancia en los resultados metabólicos (control de diabetes) del paciente Este nuevo estómago que obtendremos, reduce la cantidad de alimento que el paciente puede comer, sintiéndose satisfecho con pequeñas porciones de alimento, además de reducir la secreción de la hormona del apetito, llamada grelina.

Es importante saber que, después de esta cirugía, el estómago
conservará sus funciones digestivas normales, sin alterar la absorción de nutrientes como vitaminas y proteínas, ya que no existe un cambio anatómico del tránsito intestinal. En esta cirugía no son necesarios los “ajustes” como en la banda gástrica
Como en todos los procedimientos de pérdida de peso, es necesario que el paciente se incorpore a un protocolo preoperatorio donde será valorado, aparte del cirujano bariatra, por un nutriólogo bariatra, psicóloga, y médicos internistas calificados para la atención integral del paciente con sobrepeso y obesidad
La manga gástrica tiene especial importancia en el tratamiento de pacientes con hígado graso, ya que mejora la función hepática y permite el fácil metabolismo de las grasas para evitar almacenarse en el hígado mismo

Si estás considerando a la Manga Gástrica como un procedimiento que puede mejorar tu calidad de vida, así como otros procedimientos bariátricos, te recomiendo agendar una cita para obtener la mejor información directo de un especialista en cirugía bariátrica


Cirugía Bariatrica y Metabólica:
- Manga Gástrica - Bypass Gástrico


- MiniBypass Gástrico - Balón Intragástrico
- SADIS - Cirugía de Conversión/Revisión






Cirugía Gastrointestinal por Mínima Invasión:
- Cirugía Antirreflujo
- Cirugía de Vesícula Biliar
- Apendicectomía
- Cirugía de Hernias
- Cirugía Compleja y Gastrointestinal


info@ doctores .mx los .com 19
Manga Gástrica:
cirugía bariátrica-metabólica más realizada a nivel mundial Dr.
Carlos Reza Moreno Dr. Carlos Reza Moreno
Céd. Prof. 6812111 UADY Céd. Esp. 9239719 Cirugía Bariátrica Consultorio 15 Calle 17 No.104-A Interior N-1 Col. Vista Alegre C.P. 97130 Plaza Up Town, Mérida Yucatán. Dr. Carlos Reza Moreno dr.carlosrezamoreno carlosrezza@gmail.com 9992 55 77 33
Por: Dr. Carlos Reza Moreno














































Cirugía Plástica Estética y Reconstructiva AUMENTO DE BUSTO AUMENTO DE GLÚTEO Edificio Cenit. Consult. 1012, piso 10, Calle 15 No. 501 por 18 y 22, Altabrisa Tel. 429 16 86 Cel. 9992 336244 LIPOESCULTURA ABDOMINOPLASTIA CIRUGÍA FACIAL Professiona Center @cirugiaplastica_drgallareta Dr. José María Gallareta Bibiloni Oficial Ced. Prof. 6244315 Ced. Espec. 10451940 Permiso de publicidad 31PO0012018 Merida DESCARGA LA NUEVA APP La App mas saludable Ventas 9995 46 9452 la app mas saludable Gratis y Segura LOS DOCTORES LosDoctores D ctores Los Revista ENCUENTRA TU REVISTA GRATUITAMENTE EN LOS SIGUIENTES LUGARES
DE LA PLAZA UP TOWN Merida
DENTRO